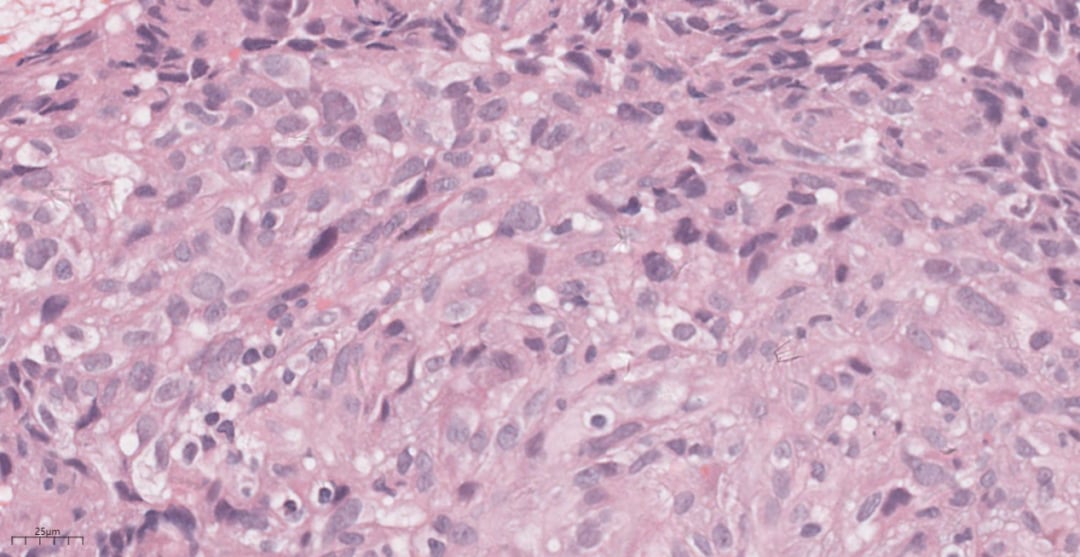
图片

引言:罕见癌症的诊断挑战
肺血管肉瘤,作为一种罕见的恶性肿瘤,可分为原发性和转移性。其中,肝血管肉瘤转移至肺部的情况尤为罕见,其恶性程度高、进展迅速,且临床表现不具特异性,极易被误诊为其他肺部疾病,如转移癌、非小细胞肺癌等。因此,对于此类罕见且侵袭性强的肿瘤,早期、精准的病理诊断显得尤为关键,它不仅能为患者争取宝贵的治疗时间,也为后续的治疗方案选择提供了重要依据。本文将通过一例详细的临床病例,深入探讨肺的转移性肝血管肉瘤的诊断过程、病理特征及治疗挑战,希望能为广大癌症患者和临床医生提供有价值的参考。
病例回顾:一位46岁男性的求医之路
一位46岁男性患者,因持续“咳嗽、咳痰、痰中带血”长达4个多月入院就诊。患者既往病史显示,3年前曾在我院接受肝脏手术,术后病理诊断明确为肝血管肉瘤,但术后并未接受放化疗。入院后,胸部CT检查结果提示右肺上叶存在两个结节状高密度影,其中较大者直径已达20mm,这引起了临床医生的高度警惕。
诊断解析:从细胞到分子层面的证据
为了明确肺部病变的性质,医生对患者进行了全面的细胞学及组织病理活检,并结合免疫组化和分子遗传学分析,最终揭示了肿瘤的真实面貌。
1. 细胞DNA倍体检测与细胞学刷片:
细胞DNA倍体检测发现存在DNA倍体异常细胞(≥3)18个,提示细胞增殖异常。支气管镜刷片检查在低倍镜下可见血性背景中成簇的梭形细胞,排列拥挤、重叠。高倍镜下,这些梭形细胞表现出显著的异型性,局部可见小的肿瘤细胞群呈现血管形态,细胞质强嗜碱性,边界不清,并含有小的点状空泡。液基细胞学检查也查见恶性肿瘤细胞,进一步提示间叶来源恶性肿瘤的可能性,并建议进行活检以明确类型。

图1 细胞DNA倍体分析发现DNA倍体异常细胞。

图2 刷检细胞学检查:高倍镜下见梭形细胞异型性显著,局灶见小的肿瘤细胞群展现出血管形态,含有小的点状空泡。(巴氏染色)

图3 液基细胞学检查:高倍镜下查见少量异型细胞,染色质细腻。(巴氏染色)
2. 组织病理活检与镜下观:
穿刺组织大体观为灰白组织一堆,约3×2×1mm。镜下观显示肿瘤细胞弥漫分布呈片状,部分区域可见较多出血。高倍镜下,肿瘤细胞呈梭形、多边形或卵圆形,具有显著异型性,胞界不清,细胞核呈梭形或卵圆形,可见小核仁。胞质嗜碱性,少许呈空泡状,病理性核分裂像易见,局灶可见坏死。部分区域似有形成血管腔的趋势,腔内可见红细胞。

图4 组织学检查:低倍镜下见肿瘤弥漫分布呈片状。

图5 组织学检查:高倍镜下见肿瘤细胞呈梭形、多边形或卵圆形,细胞具有异型性。

图6 高倍镜下局灶见坏死;部分区域似有形成血管腔的趋势。
3. 免疫组化与分子遗传学:
免疫组化结果显示,肿瘤细胞Vimentin(+)证实为间叶来源;CD31(+)、CD34(+)、F8(+)则明确了其血管源性肿瘤的性质。同时,CK(-)、D2-40(-)、Desmin(-)、Dog-1(-)、S-100(-)、SMA(-)等阴性结果排除了上皮来源肿瘤(如转移癌、非小细胞肺癌)、间皮瘤、淋巴管来源、平滑肌来源、胃肠道间质瘤等。Ki67(60%+)的高表达提示肿瘤增殖活性极强。这些免疫表型特征有力支持了肺的转移性肝血管肉瘤的诊断。

图7 免疫组化示肿瘤细胞CD31(+)

图8 免疫组化示肿瘤细胞CD34(+)

图9 免疫组化示肿瘤细胞F8(+)
图10 免疫组化示肿瘤细胞Ki67(60%+)
在分子遗传学层面,TP53基因突变在血管肉瘤中较为常见,C-MYC基因扩增则多见于放射治疗后和淋巴水肿相关的血管肉瘤。此外,抑癌基因PTEN的失活也与多种实体癌的血管生成有关,其与血管肉瘤的关系亦有报道。
病理诊断:肺的转移性肝血管肉瘤。
鉴别诊断:避免误诊的关键
由于肺的转移性肝血管肉瘤极其罕见,在临床和病理诊断中极易与其他肺部病变混淆。准确的鉴别诊断对于制定正确的治疗方案至关重要。以下是主要的鉴别诊断要点:
- 原发性肺血管肉瘤:两者在病理组织学形态和免疫组化上可能相似,但转移性肺血管肉瘤可通过临床病史和影像学检查发现原发病灶(如本例的肝脏病变)。
- 良性血管瘤:虽然免疫组化标记相似,但良性血管瘤血管腔结构明显,肿瘤细胞无明显异型性,通常无明显坏死和核分裂像,Ki67增殖指数较低。
- 转移癌:当血管肉瘤呈现上皮样形态或分化较差时,需与转移癌鉴别。转移癌通常表达上皮细胞标记物(如CK),而不表达血管内皮细胞标记物。
- 非小细胞肺癌:肺部最常见的恶性肿瘤。分化差的非小细胞肺癌可能缺乏典型的角化珠或腺样结构,与血管肉瘤在形态上可能混淆。但非小细胞肺癌通常CK、TTF-1、p63等上皮标记阳性,而血管内皮细胞标记阴性,可通过免疫组化鉴别。
- 肺上皮样血管内皮瘤:两者都可表现为上皮样细胞形态。肺上皮样血管内皮瘤少数病例虽有异型性、核分裂像和坏死,但其具有黏液玻璃样的特征性间质。此外,两者在细胞遗传学上存在显著差异,如肺上皮样血管内皮瘤常伴有WWTR-CAMTA1或YAP-TFE3基因融合,而血管肉瘤则无。
治疗与预后:挑战与希望
肺的转移性肝血管肉瘤是一种高度恶性肿瘤,进展迅速,患者的平均生存期较短。目前,治疗方案面临诸多挑战:
传统化疗,如阿霉素、甲氨蝶呤、紫杉醇等细胞毒性药物虽有报道用于治疗,但其副作用较大,且疗效往往不显著,仅适用于身体状况良好的患者。该病对放化疗的敏感性不高,导致预后普遍较差。
近年来,新型血管靶向药物,特别是血管内皮生长因子受体(VEGFR)抗体药物,已被尝试用于治疗此类疾病,但其疗效仍有待进一步提升。这凸显了精准治疗的重要性,即根据肿瘤的分子特征选择最合适的治疗方案。
对于面临复杂癌症诊断和治疗选择的患者,获取全面的药物信息和专业的AI问诊服务至关重要。MedFind提供AI问诊服务,帮助患者更好地理解病情和治疗方案。
面对海外靶向药和抗癌药的需求,患者往往面临购药难题。MedFind作为专业的海外靶向药代购网站,致力于为癌症患者提供便捷、可靠的海外购药途径,涵盖多种抗癌药和靶向药,包括可能对血管肉瘤有效的新型靶向药物。同时,我们还提供丰富的药物信息和诊疗指南等抗癌资讯,助力患者做出明智的治疗决策。
若病理医生能够及时且准确诊断,并报道更多相关病例,将有助于积累宝贵的临床数据和资料,从而推动该类患者的精准治疗发展,最终提高其生存期。
参考文献:
[1]Molina E, Hernandez A. Clinical manifestations of primary hepatic angiosarcoma[J]. Digestive diseases and sciences, 2003, 48: 677-682.
[2]Penel N ,Sandrine Marréaud, Robin Y M ,et al.Angiosarcoma: state of the art and perspectives.[J].Critical Reviews in Oncology/hematology, 2011, 80(2):257-263.
[3]H,P,Wang,et al.Pulmonary metastatic angiosarcoma presenting with diffuse alveolar hemorrhage:9 case reports[J].China Medical Abstracts(Internal Medicine), 2018, 35(03):35-36.
[4]Pandit S A , Fiedler P N , Westcott J L .Primary angiosarcoma of the lung[J].Annals of Diagnostic Pathology, 2005, 9(5):302-304.
[5]Yogi A, Miyara T, Ogawa K, et al. Pulmonary metastases from angiosarcoma: a spectrum of CT findings[J]. Acta Radiologica, 2016, 57(1): 41-46.
[6]Hod N, Shalev A, Levin D, et al. FDG PET/CT of cardiac angiosarcoma with pulmonary metastases[J]. Clinical Nuclear Medicine, 2018, 43(10): 744-746.
[7]Tate G , Suzuki T , Mitsuya T .Mutation of the PTEN gene in a human hepatic angiosarcoma[J].Cancer Genetics & Cytogenetics, 2007, 178(2):160-162.
